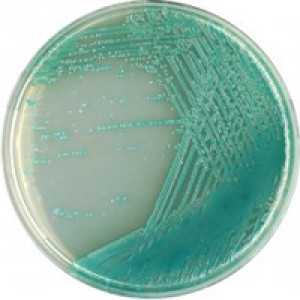

Performance
Pseudomonas are ubiquitous bacteria found in the soil, on plants, in freshwater and marine habitats. Many strains can grow at low temperature (psychrophilic strains) and may contaminate food or pharmaceutical products stored in the refrigerator.
P. aeruginosa is a valid indicator for recreational water disinfection efficacy. This parameter is currently used as a criterion in the regulation of wading and swimming pools. Moreover, P. aeruginosa is important not only in terms of its role as an indicator, but also because it is an opportunistic pathogen whose transmission is often associated with water.
Other forms of Pseudomonas bacteria are known to cause food spoilage at low temperatures. These psychrophillic Pseudomonas strains include: P. fragi, which causes spoilage of dairy products, P. taetrolens which causes mustiness in eggs and P. mudicolens and P. lundensis, which cause spoilage of milk, cheese, meat, and fish, but are rarely a cause of food poisoning.